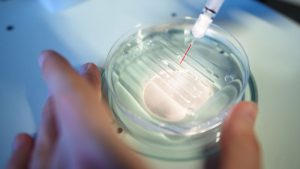
Changing our DNA: 'The age of human therapeutic gene editing is here' - CNN

Articles categorized by "Weather"
Latest
-
Wegman uses biometric surveillance on shoppers, raising privacy concerns
-
UK ordered agents to find UFO tech in bombshell 1990s secret files shocker | New York Post
-
Private equity barons target savers in hunt for ‘the perfect bailout’
-
Giant structure discovered deep beneath Bermuda is unlike anything else on Earth | Live Science